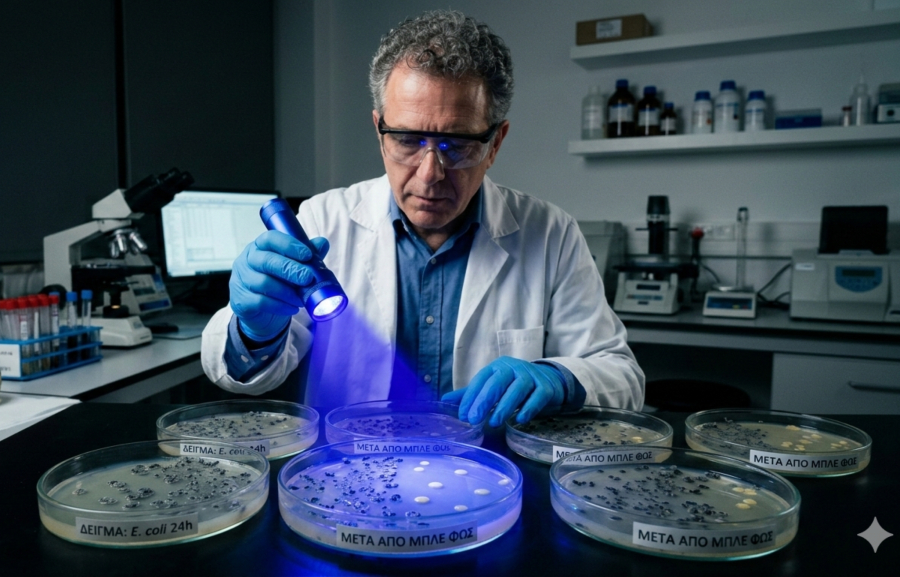

Τα βακτήρια μπορεί να είναι από τις πιο απλές μορφές ζωής, όμως τα τελευταία χρόνια αποδεικνύονται εξαιρετικά… πανούργα. Όλο και συχνότερα καταφέρνουν να ξεγλιστρούν από τα αντιβιοτικά που κάποτε τα εξόντωναν με ευκολία.
Ένα χαρακτηριστικό παράδειγμα είναι ο χρυσίζων σταφυλόκοκκος MRSA, που μπορεί να μετατρέψει μια μικρή εκδορά σε επίμονη, πυώδη λοίμωξη και, στη χειρότερη των περιπτώσεων, σε σήψη. Κολλάει σε επιφάνειες, επιβιώνει σε νοσοκομεία και πλήττει κυρίως τους πιο ευάλωτους ασθενείς. Το πιο ανησυχητικό όμως είναι ότι ανήκει στα «υπερ-μικρόβια» που αναπτύσσουν αντοχή σε πολλά αντιβιοτικά.
Όπως εξηγεί ο Jeffrey Gelfand στο Γενικό Νοσοκομείο της Μασαχουσέτης, τα βακτήρια έχουν αναπτύξει πολλαπλούς μηχανισμούς αντίστασης, καθιστώντας λοιμώξεις όπως αυτές από MRSA ολοένα και πιο δύσκολες στη θεραπεία. Ορισμένες προβλέψεις μάλιστα εκτιμούν ότι μέχρι το 2050 τα ανθεκτικά παθογόνα μπορεί να προκαλούν περισσότερους θανάτους από τον καρκίνο!
Μέσα σε αυτή τη ζοφερή πραγματικότητα, μια απρόσμενη ελπίδα έρχεται από κάτι απλό και καθημερινό, από το μπλε φως. Αυτή την προσέγγιση διερευνά ο Gelfand για την αντιμετώπιση του MRSA και άλλων υπερμικροβίων.
Φανταστείτε μια συσκευή που μοιάζει με επίδεσμο από σιλικόνη. Το ενεργό συστατικό της δεν είναι αντιβιοτικό ή άλλο φάρμακο, αλλά μικροσκοπικά LED ενσωματωμένα στη σιλικόνη που λάμπουν σε συγκεκριμένα μήκη κύματος.
Ο Gelfand μαζί με τη Laisa Negri, ερευνήτρια δερματολογίας και με άλλους συναδέλφους του στο Κέντρο Φωτοϊατρικής Wellman του Γενικού Νοσοκομείου της Μασαχουσέτης, που είναι το μεγαλύτερο ακαδημαϊκό κέντρο έρευνας παγκοσμίως για τις επιδράσεις του φωτός στη βιολογία, έχουν αναπτύξει μια τέτοια συσκευή.
Το νέο ‘εργαλείο’ βασίζεται σε έρευνα του σε προκλινικά μοντέλα που διεξήχθη για περισσότερο από μια δεκαετία, η οποία αποκαλύπτει ότι το μπλε φως μπορεί να περιορίσει ακόμη και τα πιο επίμονα βακτηριακά παθογόνα.
Εάν αποδειχθεί βιώσιμη στους ανθρώπους, η προσέγγιση αυτή θα μπορούσε να προσθέσει μια σπάνια νέα επιλογή σε ένα οπλοστάσιο κατά των ανθεκτικών λοιμώξεων, το οποίο συνεχώς συρρικνώνεται.
Το μπλε φως σύμμαχος της Ιατρικής
Στο Κέντρο Φωτοϊατρικής Wellman ένας άλλος ερευνητής, ο Tianhong Dai μελετά εδώ και χρόνια το πώς συγκεκριμένα μήκη κύματος φωτός μπορούν να εξοντώσουν βακτήρια. Το μπλε φως, σε μήκη κύματος περίπου 405–470 νανομέτρων, ανήκει στο ορατό φάσμα και δεν βλάπτει άμεσα το DNA των ανθρώπινων κυττάρων, σε αντίθεση με την υπεριώδη ακτινοβολία.
Σε εργαστηριακά πειράματα που δημοσιεύθηκαν το 2013, ο Dai και η ομάδα του φώτισαν καλλιέργειες MRSA με μπλε φως. Το αποτελέσματα ήταν εντυπωσιακά, σπασμένα κυτταρικά τοιχώματα, κατεστραμμένες μεμβράνες, βακτήρια κυριολεκτικά διαλυμένα. Σε πειράματα σε ζώα, το μπλε φως κατάφερε να αναστείλει την ανάπτυξη του ανθεκτικού μικροβίου σε μολυσμένα τραύματα.
Ο Dai συνέχισε να διεξάγει δεκάδες μελέτες για την επίδραση του μπλε φωτός σε μια σειρά μικροβίων και απέδειξε την αποτελεσματικότητά του έναντι του Acinetobacter baumannii για παράδειγμα, ενός υπερβακτηρίου που είναι γνωστό ότι μολύνει τραύματα στρατιωτών σε μάχες, καθώς και παθογόνων μυκήτων που ευδοκιμούν παράλληλα με βακτήρια σε κολλώδη βιοφίλμ. Στην πορεία, χρησιμοποίησε έξυπνα εργαλεία, όπως φθορίζοντα μόρια που μπορούν να λάμπουν μέσα στα βακτήρια και λεκέδες που αποκαλύπτουν κατεστραμμένο DNA για να βοηθήσει στην αποσαφήνιση του τρόπου με τον οποίο το μπλε φως βλάπτει τα βακτήρια.
Το μυστικό βρίσκεται σε μόρια που ονομάζονται πορφυρίνες, τα οποία απορροφούν έντονα το μπλε φως και υπάρχουν σε πολλά βακτήρια σε υψηλά επίπεδα. Όταν τα μόρια «διεγερθούν» από το φως, παράγουν δραστικές μορφές οξυγόνου, δηλαδή εξαιρετικά αντιδραστικά μόρια που διαλύουν μεμβράνες, καταστρέφουν DNA και οξειδώνουν πρωτεΐνες και λιπίδια. Η ζημιά είναι πολυμέτωπη και συσσωρευτική, καθώς το βακτήριο δεν έχει έναν μόνο «στόχο» για να αντιδράσει και να σωθεί με μια μετάλλαξη, όπως συμβαίνει με τα αντιβιοτικά. Αυτό καθιστά πολύ πιο δύσκολη την ανάπτυξη αντοχής. Ο Dai διεξήγε μάλιστα πειράματα εκθέτοντας βακτηριακές κοινότητες σε επαναλαμβανόμενους κύκλους φωτός για να προσπαθήσει να προκαλέσει αντοχή, αλλά δεν διαπίστωσε μείωση της αποτελεσματικότητας της θεραπείας με την πάροδο του χρόνου.
Ακόμη πιο ενθαρρυντικό είναι ότι τα ανθρώπινα κύτταρα φαίνεται να μην επηρεάζονται ιδιαίτερα, γιατί περιέχουν χαμηλότερα επίπεδα πορφυρινών και διαθέτουν ισχυρότερους μηχανισμούς άμυνας απέναντι στο οξειδωτικό στρες.
Ωστόσο, ορισμένες μελέτες έχουν δείξει ότι υψηλότερες δόσεις μπλε φωτός μπορούν να επηρεάσουν τα επίπεδα ενέργειας των ανθρώπινων κυττάρων ή την ικανότητά τους να αντιμετωπίζουν το οξειδωτικό στρες, για αυτό οι ερευνητές τονίζουν ότι χρειάζεται προσεκτικός καθορισμός των «θεραπευτικών παραθύρων», δηλαδή των δόσεων που είναι αποτελεσματικές για τα μικρόβια και ταυτόχρονα ασφαλείς για τον άνθρωπο.
Ένας φωτεινός επίδεσμος
Η έρευνα όμως δεν σταματά εκεί. Μια άλλη επιστήμονας η Δρ Mei X. Wu, καθηγήτρια δερματολογίας στο Γενικό Νοσοκομείο της Μασαχουσέτης, αναζήτησε τρόπους για να ενισχύσει τις επιδράσεις του μπλε φωτός ώστε να μειώσει τις δόσεις που απαιτούνται για τη θεραπεία σύνθετων λοιμώξεων.
Σε μελέτη που δημοσιεύθηκε στο Nature Communications, ο συνδυασμός ήπιας δόσης μπλε φωτός με καρβακρόλη, μια δραστική ουσία της ρίγανης, εξόντωσε έως και 80.000 φορές περισσότερα βακτήρια MRSA σε σχέση με το φως από μόνο του. Η καρβακρόλη λειτουργεί ως «ενισχυτής», πολλαπλασιάζοντας την παραγωγή των καταστροφικών μορφών οξυγόνου μέσα στα βακτήρια.
Μάλιστα, η Wu υποστηρίζει ότι ίσως το μπλε φως να ήταν ανέκαθεν και πριν καν το αντιληφθούμε σύμμαχος της παραδοσιακής ιατρικής. Παλαιότερα οι άνθρωποι περνούσαν πολύ περισσότερο χρόνο στον ήλιο και έως και όπως είναι γνωστό, το 1/3 του φυσικού φωτός της ημέρας βρίσκεται στο μπλε φάσμα. Ίσως αυτό εξηγεί γιατί ορισμένα φυτά που χρησιμοποιούνταν για λοιμώξεις στο παρελθόν φαίνονται λιγότερο αποτελεσματικά στα σύγχρονα εργαστήρια, μακριά από το φυσικό φως.
Το μεγάλο ερώτημα είναι πότε όλα αυτά θα περάσουν από το εργαστήριο στην κλινική πράξη. Το 2025, η ομάδα του Gelfand δοκίμασε μια πιο ισχυρή εκδοχή της συσκευής σε μολυσμένα τραύματα χοίρων, σε ένα μοντέλο που προσεγγίζει πολύ το ανθρώπινο δέρμα. Με καθημερινή έκθεση περίπου 90 λεπτών, τα επίπεδα του MRSA μειώθηκαν πάνω από 99,99% μέσα σε δύο ημέρες. Πρόκειται για το πρώτο δημοσιευμένο πείραμα τέτοιου τύπου σε μεγάλο ζωικό μοντέλο.
Φυσικά, απομένουν να γίνουν σημαντικά βήματα, όπως η βελτίωση του σχεδιασμού της συσκευής, η μείωση του κόστους και η λεπτομερής αξιολόγηση τυχόν παρενεργειών. Όμως η κατεύθυνση είναι σαφής. Συσκευές που εκπέμπουν φως εξελίσσονται ήδη ώστε να φτάνουν σε σημεία όπου το φως δεν φτάνει εύκολα.
Για παράδειγμα, ο Dai και οι συνάδελφοί του αναπτύσσουν έναν ωτοσωλήνα με ενσωματωμένο ένα μικροσκοπικό λαμπερό λέιζερ που θα μπορούσε κάποια μέρα να χρησιμοποιηθεί για την καταπολέμηση των βακτηριακών βιοφίλμ που προκαλούν υποτροπιάζουσες ωτολοιμώξεις σε παιδιά. Στο Γενικό Νοσοκομείο της Μασαχουσέτης ορθοπεδικοί χειρουργοί δημιούργησαν μια οπτική ίνα με τη δυνατότητα να φωτίζει χώρους μέσα στο σώμα, όπως γύρω από εμφυτεύματα αρθρώσεων, για να σταματήσουν τις ανθεκτικές στα φάρμακα λοιμώξεις. Ορισμένες συσκευές μπλε φωτός έχουν ήδη εγκριθεί και χρησιμοποιούνται για τη θεραπεία της ακμής σε ανθρώπους, αλλά αυτοί οι τύποι συσκευών χρησιμοποιούν χαμηλότερη ισχύ φωτός από αυτήν που μελετάται τώρα.
Ωστόσο, οι επιστήμονες διευκρινίζουν ότι το μπλε φως δεν προορίζεται να αντικαταστήσει τα αντιβιοτικά. Στόχος είναι να τα ενισχύσει, να μειώσει τη διάρκεια και τη δόση τους και να περιορίσει την εμφάνιση νέας αντοχής. Σε μια εποχή όπου τα «υπερμικρόβια» απειλούν να μας γυρίσουν πίσω σε μια προ-αντιβιοτική εποχή, κάθε νέο όπλο έχει τεράστια σημασία.
Και ίσως, τελικά, η λύση σε ένα από τα πιο σύνθετα ιατρικά προβλήματα του 21ου αιώνα να κρύβεται σε κάτι τόσο απλό, στο φως που ανάβει με το πάτημα ενός διακόπτη.
*Με πληροφορίες από το Harvard Medicine